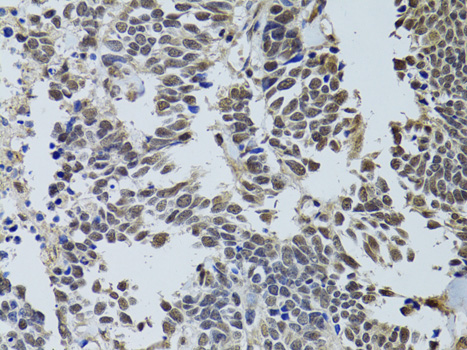
Immunohistochemistry - LKB1 Polyclonal Antibody

-
Product Name
LKB1 Polyclonal Antibody
- Documents
-
Description
Polyclonal antibody to LKB1
-
Tested applications
WB, IHC, IF
-
Species reactivity
Human, Mouse, Rat
-
Alternative names
STK11 antibody; LKB1 antibody; PJS antibody; hLKB1 antibody; serine/threonine kinase 11 antibody
-
Isotype
Rabbit IgG
-
Preparation
Antigen: Recombinant fusion protein containing a sequence corresponding to amino acids 134-433 of human LKB1 (NP_000446.1).
-
Clonality
Polyclonal
-
Formulation
PBS with 0.02% sodium azide, 50% glycerol, pH7.3.
-
Storage instructions
Store at -20℃. Avoid freeze / thaw cycles.
-
Applications
WB 1:500 - 1:2000
IHC 1:50 - 1:200
IF 1:50 - 1:200 -
Validations

Western blot - LKB1 Polyclonal Antibody
Western blot analysis of extracts of various cell lines, using LKB1 antibody at 1:1000 dilution.Secondary antibody: HRP Goat Anti-Rabbit IgG (H+L) at 1:10000 dilution.Lysates/proteins: 25ug per lane.Blocking buffer: 3% nonfat dry milk in TBST.Detection: ECL Basic Kit .Exposure time: 10s.
Immunohistochemistry - LKB1 Polyclonal Antibody
Immunohistochemistry of paraffin-embedded human lung cancer using LKB1 antibody at dilution of 1:100 (40x lens).

Immunohistochemistry - LKB1 Polyclonal Antibody
Immunohistochemistry of paraffin-embedded human colon carcinoma using LKB1 antibody at dilution of 1:100 (40x lens).

Immunohistochemistry - LKB1 Polyclonal Antibody
Immunohistochemistry of paraffin-embedded human uterine cancer using LKB1 antibody at dilution of 1:100 (40x lens).

Immunohistochemistry - LKB1 Polyclonal Antibody
Immunohistochemistry of paraffin-embedded human esophageal cancer using LKB1 antibody at dilution of 1:200 (40x lens).
-
Background
Tumor suppressor serine/threonine-protein kinase that controls the activity of AMP-activated protein kinase (AMPK) family members, thereby playing a role in various processes such as cell metabolism, cell polarity, apoptosis and DNA damage response. Acts by phosphorylating the T-loop of AMPK family proteins, thus promoting their activity: phosphorylates PRKAA1, PRKAA2, BRSK1, BRSK2, MARK1, MARK2, MARK3, MARK4, NUAK1, NUAK2, SIK1, SIK2, SIK3 and SNRK but not MELK. Also phosphorylates non-AMPK family proteins such as STRADA, PTEN and possibly p53/TP53. Acts as a key upstream regulator of AMPK by mediating phosphorylation and activation of AMPK catalytic subunits PRKAA1 and PRKAA2 and thereby regulates processes including: inhibition of signaling pathways that promote cell growth and proliferation when energy levels are low, glucose homeostasis in liver, activation of autophagy when cells undergo nutrient deprivation, and B-cell differentiation in the germinal center in response to DNA damage. Also acts as a regulator of cellular polarity by remodeling the actin cytoskeleton. Required for cortical neuron polarization by mediating phosphorylation and activation of BRSK1 and BRSK2, leading to axon initiation and specification. Involved in DNA damage response: interacts with p53/TP53 and recruited to the CDKN1A/WAF1 promoter to participate in transcription activation. Able to phosphorylate p53/TP53; the relevance of such result in vivo is however unclear and phosphorylation may be indirect and mediated by downstream STK11/LKB1 kinase NUAK1. Also acts as a mediator of p53/TP53-dependent apoptosis via interaction with p53/TP53: translocates to the mitochondrion during apoptosis and regulates p53/TP53-dependent apoptosis pathways. In vein endothelial cells, inhibits PI3K/Akt signaling activity and thus induces apoptosis in response to the oxidant peroxynitrite (in vitro). Regulates UV radiation-induced DNA damage response mediated by CDKN1A. In association with NUAK1, phosphorylates CDKN1A in response to UV radiation and contributes to its degradation which is necessary for optimal DNA repair.; Isoform 2: Has a role in spermiogenesis.
Related Products / Services
Please note: All products are "FOR RESEARCH USE ONLY AND ARE NOT INTENDED FOR DIAGNOSTIC OR THERAPEUTIC USE"
